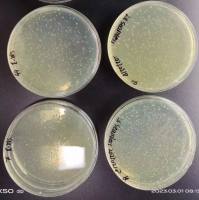

农杆菌感受态的制备和转化
互联网
双元载体的农杆菌转化
1.1农杆菌感受态细胞的制备
1.1.1. 取-70℃保存的EHA105于含50μg/ml链霉素平板划线,28℃培养。
1.1.2. 挑取单菌落接种于5ml YM液体培养基中,220rpm 28℃振荡培养12-16 hr。
1.1.3. 取2ml菌液转接于100ml YM液体培养基中,28℃220rpm振荡培养至OD600 =0.5。
1.1.4. 转入无菌离心管,5000rpm离心5min,去上清液。
1.1.5. 加入10ml预冷的0.1M的CaCl2 溶液,轻轻悬浮细胞,冰上放置20min。4℃5000rpm离心5min,去上清。
1.1.6. 加入4ml预冷的含15%甘油的0.1M的CaCl2 溶液,轻轻悬浮。
1.1.7. 农杆菌悬浮液分装于无菌Eppendorf管中,每管200μl冻存于-70℃。
1.2. 双元载体转化农杆菌EHA105
取1μg左右的质粒DNA加入到200ml EHA105感受态细胞中,混匀后,冰浴30min,-70℃放置10min 。再在37℃水浴5min或42℃水浴1min,接着冰浴2min,加入800mlYM液体培养基28℃,175rpm摇培3hr后涂在含50μg/ml Kanamycin的YM平板上。28℃培养到形成单菌落。
其中 YM 可以用LB 代替 ,第一次的 CaCl2 溶液可用溶液(0.1MCaCl2 0.01Tris-HCl(7.0) 0.01 DTT)替代。